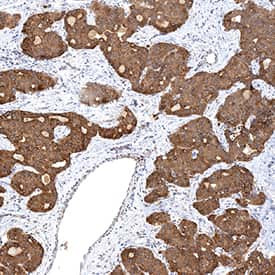
SMO Antibody in Immunohistochemistry (Paraffin) (IHC (P))

Search
Invitrogen
SMO Monoclonal Antibody (1015418)
{{$productOrderCtrl.translations['antibody.pdp.commerceCard.promotion.promotions']}}
{{$productOrderCtrl.translations['antibody.pdp.commerceCard.promotion.viewpromo']}}
{{$productOrderCtrl.translations['antibody.pdp.commerceCard.promotion.promocode']}}: {{promo.promoCode}} {{promo.promoTitle}} {{promo.promoDescription}}. {{$productOrderCtrl.translations['antibody.pdp.commerceCard.promotion.learnmore']}}
产品信息
MA5-60873
种属反应
宿主/亚型
分类
类型
克隆号
抗原
偶联物
形式
浓度
规格
纯化类型
保存液
内含物
保存条件
运输条件
RRID
产品详细信息
Reconstitute at 0.5 mg/mL in sterile PBS.
靶标信息
Smoothened drosophila homolog (SMOH) is a serpentine protein belonging to the G-protein coupled receptor Fz/Smo family with 787 aa, seven transmembrane G protein-coupled receptors with 4 glycosylation sites and a putative extracellular amino terminus. Smoothened activated by b-Arrestin 2 and GRK2 acts as a receptor for Shh, the Sonic hedgehog gene product, and is a positive regulator of hedgehog signaling pathway along with the smoothened inhibitor patched protein (PTCH) and regulates vertebrate developmental processes, cellular proliferation and differentiation by activating transcription factor Gli. Smoothened mutants are known to cause sporadic basal cell carcinoma of the skin. It is known to express widely in heart and brain.
仅用于科研。不用于诊断过程。未经明确授权不得转售。
篇参考文献 (0)
生物信息学
蛋白别名: candidate receptor for sonic hedgehog; frizzled family member 11; HGNC:11119; Protein Gx; Protein SMOH; Protein smoothened; seven transmembrane helix receptor; smoothened homolog; smoothened, frizzled family receptor; smoothened, seven transmembrane spanning receptor
基因别名: CRJS; FZD11; Gx; PHLS; SMO; SMOH
UniProt ID: (Human) Q99835
Entrez Gene ID: (Human) 6608